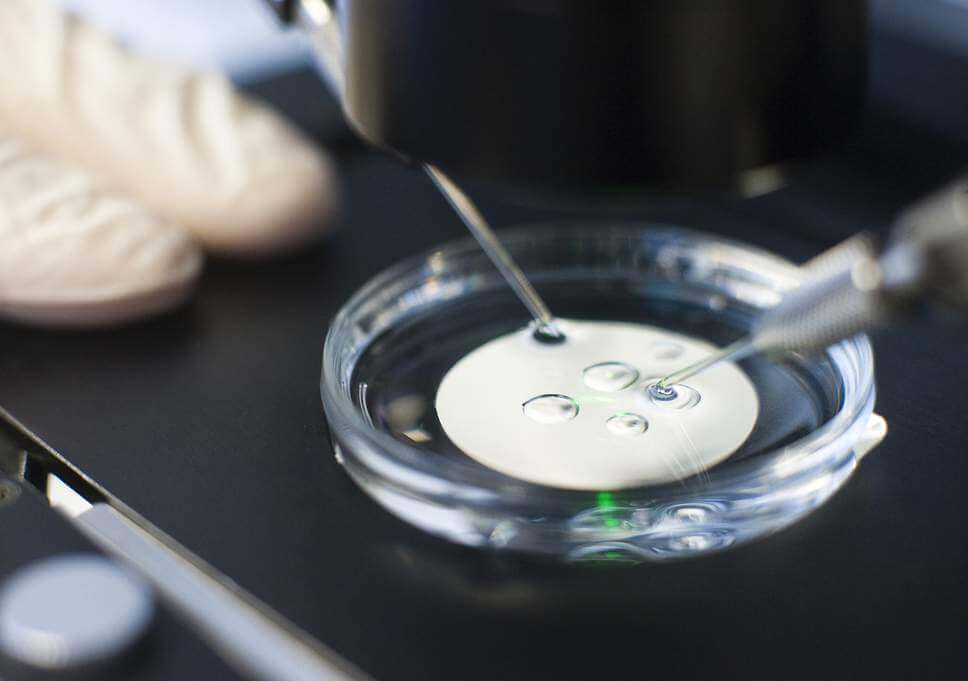
IVF Rex

The possibility of “CRISPR babies” became real [November 25], when a Chinese scientist stunned the world by announcing he’d used the gene-editing technology to alter the embryos of two baby girls.
…
Meanwhile, another nagging question has lingered: Are there more scientists out there using CRISPR to tweak genes in embryos intended for pregnancy — and could clinics offering to CRISPR babies show up in the US any time soon?
In an article in Stat [December 3], the University of California Davis School of Medicine stem cell biologist Paul Knoepfler argued that we will see IVF clinics using CRISPR because we’ve already seen stem cell clinics offering non-FDA approved therapies proliferate.
…
Just because it’s illegal, however, doesn’t mean people won’t do it, Knoepfler argues. Hank Greely, a Stanford law professor who has been studying CRISPR, meanwhile takes the opposite view that we shouldn’t expect CRISPR babies in the US anytime soon.
…
There is no shortage of examples in medicine of people exploiting the desperation of patients, offering them unproven and risky treatments. According to Knoepfler, doing so with CRISPR isn’t all that far-fetched — while [professor Hank] Greely makes a strong case that it’s both politically and logistically infeasible.
Whatever side you fall on, it’s time for scientific groups and regulatory agencies to think about whether the laws, policies, and regulations we have in place are ready for this.
Read full, original post: How soon will CRISPR gene-edited babies come to the US?